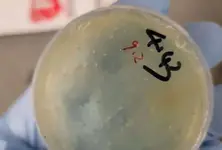
Another Chinese national arrested for smuggling ‘roundworms’ into US University of Michigan

SCIENCE-AND-TECHNOLOGY
Another Chinese national arrested for smuggling ‘roundworms’ into US University of Michigan
2025 June 10 at 04:09 AMScientists engineer ‘Woolly Mice’ with traits of mammoth in de-extinction effort
2025 March 05 at 01:04 PMHindenburg’s latest allegations state Roblox faked user numbers, compromised user safety
2024 October 09 at 06:13 PMHere’s how more screen time, no exercise may push you to digital dementia
2024 September 03 at 02:34 PMStudy compares diagnostic accuracy of ChatGPT & radiologists in musculoskeletal imaging
2024 August 23 at 07:38 AMGPAI member countries adopt New Delhi declaration on AI, its responsible use
2023 December 14 at 11:19 AM